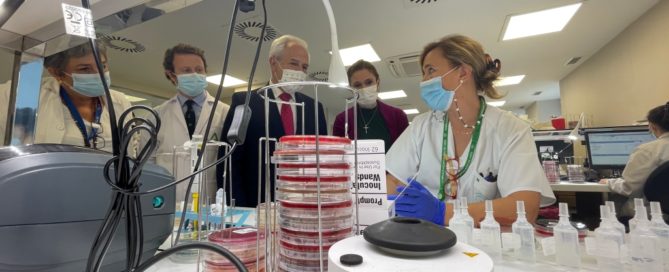

El Hospital de Jaén incorpora técnicas de secuenciación masiva aplicada tumores sólidos
PrensaHUJ2022-02-04T12:49:25+01:00El Hospital Universitario de Jaén ha implantado técnicas de secuenciación masiva, que permiten avanzar en la aplicación de la medicina de precisión en los pacientes con cáncer de la provincia. En los últimos años [...]